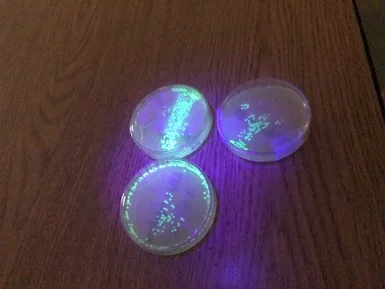

Thank You Letter for Lab Equipment
From: Carol Acree, David Douglas High School, Chemistry and Biology
June 8, 2018
Dear DDEF,
Thank you so much for purchasing the water bath and micropipetters for my class to use in 2017-2018!
Biology teachers used the micropipetters to engineer a medium to grow algae when we studied biofuels. Winning groups grew chlorella algae in the fastest amount of time with their winning "recipe". Micropipetters were required to mix unique solutions of very small nutrients into the medium. Students graphed their data and eventually will share their data with biofuel farms that use chlorella algae in an attempt to help solve global warming.
DDHS student uses the water bath to transfer the pGlo jellyfish gene into bacteria plasmid (DNA).
Growing Chlorella algae for green energy and studying biofuels. Students engineered different mediums to grow the most amount of algae in the fastest amount of time.
Genetically engineered fluorescent bacteria. DNA from a jellyfish was inserted in the bacteria to make it glow.
Biology teachers used water baths for multiple labs! It was integral to have a water bath when we engineered glowing bacteria. Students put a gene from a glowing jellyfish into bacteria to make it glow. To get the jellyfish DNA into the bacterial plasmid (DNA) students use the process of "heat shock," which requires putting the DNA and bacteria into a cuvette, then putting in the water bath at 46 degrees Celsius for 45 seconds, then ice for 1 minute. After that, students had glowing bacteria.
Students used the water baths to melt agarose and pour their own bacterial plates. Students designed their own experiments with the antibiotic ampicillin as we learned about bacterial resistance to antibiotics.